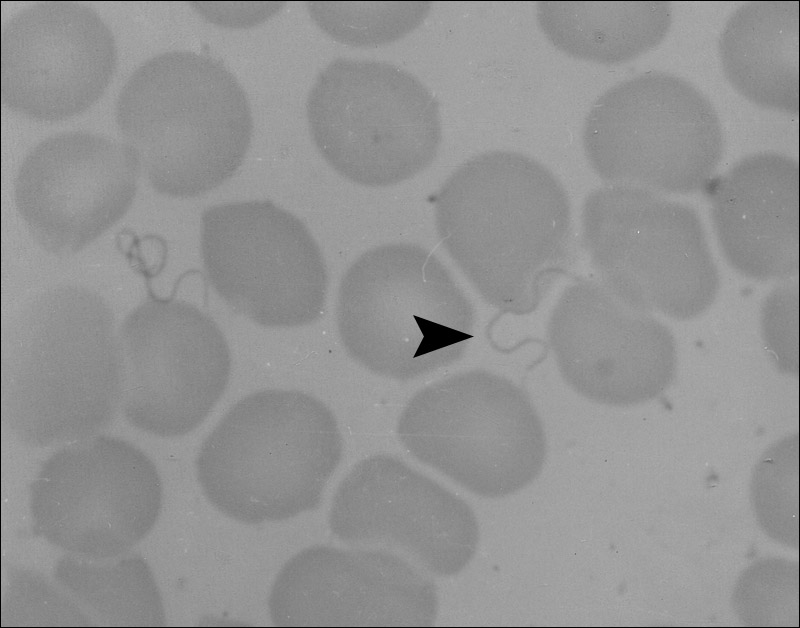
回归热疏螺旋体

伯氏疏螺旋体

伯氏疏螺旋体细菌图片下载
图片尺寸800x600
细菌伯氏疏螺旋体 recurrentis 或其他伯氏疏螺旋体
图片尺寸480x320
伯氏疏螺旋体细菌菌落
图片尺寸1200x800
疏细菌伯氏疏螺旋体 recurrentis 或其他伯氏疏螺旋体照片
图片尺寸450x300
奋森疏螺旋体图册_百度百科
图片尺寸172x220
了解螺旋体
图片尺寸1080x810
密螺旋体图片
图片尺寸450x300
微生物图谱之螺旋体
图片尺寸441x345
第17章 螺旋体〔ppt课件〕.ppt
图片尺寸1152x864
脑炎蜱,这种类型的动物是一个疏螺旋体的摊铺机和细菌伯氏疏螺旋体
图片尺寸533x300
回归热疏螺旋体
图片尺寸800x628
引起梅毒的细菌,梅毒螺旋体
图片尺寸1200x800
伯氏包柔氏螺旋体
图片尺寸265x320
borrelia recurrentisinfection 回归热螺旋体感染
图片尺寸1200x961
疏螺旋体素的制备方法
图片尺寸502x328
bufa-14,20,22-trienolide,3-(acetyloxy)-16-o
图片尺寸473x453
奋森疏螺旋体
图片尺寸220x165
assembly of metal-organic frameworks (mofs) based
图片尺寸660x486
运动的螺旋体丨gfycat回顾人类疾病史,我们会发现,除了伯氏疏螺旋体外
图片尺寸781x563
6-substituted-1,2,3,4-tetrahydro-9h-carbazoles
图片尺寸1904x724